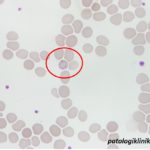
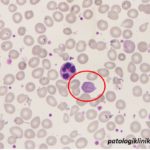
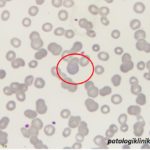
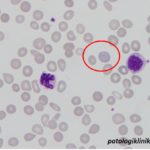

Cabot Ring
Cabot ring adalah gambaran cincin atau angka “8” tipis pada sitoplasma eritrosit berwarna merah keunguan pada pengecatan Wright.Cabot ring kebanyakan ditemui pada sitopasma eritrosit yang basofilik atau polikromasi. Bentukan cincin ini kemungkinan adalah sisa-sisa dari inti eritrosit (mitotic spindle) yang tertinggal setelah inti dikeluarkan dari normoblas.
Cabot ring dapat ditemukan pada beberapa kondisi seperti:
- anemia megaloblastik
- keracunan timbal
- anemia berat
- leukemia
- mielofibrosis
- MDS
- keadaan yang menyebabkan diseritropoiesis
- obat-obatan.